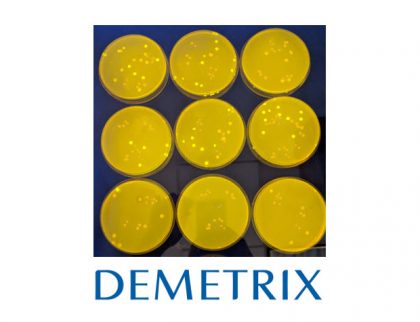

Biotechnology Company Demetrix Works Toward Cannabinoid Biosynthesis Commercialization Following $50M Series A
Exclusive Interview with Demetrix CEO Jeff Ubersax, PhD Biotechnology companies are hard at work finding ways to commercialize biosynthetic cannabinoids, and among those companies is Demetrix. CEO Jeff Ubersax...